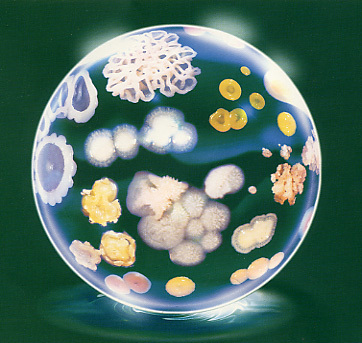

Thực phẩm hư nhưng chưa chắc đã hỏng. Hư ăn vào thường là chẳng sao, nhưng hỏng ăn vào là mắc bệnh. Cả hai đều do vi khuẩn gây ra. Nếm, ngửi, nhìn có thể nhận ra đồ ăn bị hư, nhưng lại không phát hiện ra đồ ăn bị hỏng. Đừng tưởng bở! Ngộ độc thực phẩm từ đó mà ra…
Vũ Thế Thành
Vi khuẩn thường phát triển tốt nhất ở khoảng nhiệt độ 5 đến 60 độ C. Gót chân achilles của vi khuẩn là ở chỗ này (ảnh: textbookofbacteriology.net)
Thực phẩm khi vào tới miệng,bao tử ruột rà là bị chặt đứt và chuyển hóa theo kiểu tốt lành cho con người, nhưng vi khuẩn làm hư thực phẩm (spoilage bacteria) cũng chặt đứt và chuyển hóa, nhưng theo kiểu chẳng giống ai, làm trái cây rau củ có thể bị nhũn, nhày, còn thịt thà có mùi khó chịu,.. Nói chung là mùi, vị, màu sắc, cấu trúc (dai, dòn, xốp,..) của đồ ăn lúc đó trông rất chán, thấy là hết muốn ăn. Ăn không nổi, tiếc của, vất cho chó ăn. Chó ăn vẫn khỏe re. Đâu ai thấy rằng đồ “vất cho chó ăn” này thường là vô hại, và dĩ nhiên độ dinh dưỡng của nó bị sụt giảm khá nhiều so với thửa ban đầu.
Cũng có những loại vi khuẩn lẻn vào đồ ăn rồi sinh sôi nảy nở trong đó, nhưng lại gây đau bụng, nhức đầu, sốt cao, ói mửa, thậm chí vong mạng. Nhìn lại đồ ăn, thấy nó vẫn thơm tho, nóng hổi, mượt mà, tươi tốt. Mặt sau của cái đẹp luôn luôn là con dao găm. Vi khuẩn loại này được gọi là vi khuẩn gây bệnh (pathogenic bacteria). Thử điểm mặt vài tên thường lảng vảng: E. coli, salmonella, listeria, campylobacter,…
Ngăn – Giết – Chặn
Chẳng ai thích hư và hỏng. Đồ ăn hư đã chán, hỏng lại càng đáng gờm. Phải triệt cả hai.
Trước tiên phải chặn đường xâm nhập của vi khuẩn. Nếu thua thì phải giết. Giết chưa được (chưa kịp nấu nướng), thì phải chặn không để nó sinh đẻ tràn lan. Phải nói là “ Đẻ như vi khuẩn” mới đúng. Có loại vi khuẩn chỉ trong vòng nửa tiếng đã tăng số lượng gấp đôi.
Cũng cần biết, không cứ tìm thấy vi khuẩn (có hại) trong thực phẩm là ăn vào sẽ bị ngộ độc. Vi khuẩn phải đủ số lượng nào đó mới vượt qua được hệ thống phòng vệ của cơ thể và gây hại. Do đó sự có mặt của vi khuẩn (nhiễm khuẩn) được xem là nguy cơ. Đối với an toàn thực phẩm, thì nguy cơ phải được loại bỏ.
Ngăn chặn vi khuẩn xâm nhập vào thực phẩm thì quá dễ (nhưng khó làm?), đó là vệ sinh tay, dao thớt khi làm bếp. Rau qủa củ mua ở chợ hay siêu thị là ổ vi khuẩn, nhất là E.Coli (gây tiêu chảy, sốt) có trong đất trồng rau, đó là chưa kể dự lượng thuốc trừ sâu, phân bón,…nên phải rửa sạch càng sớm càng tốt.
Vi khuẩn thường phát triển tốt nhất ở khoảng nhiệt độ 5 đến 60 độ C. Gót chân achilles của vi khuẩn là ở chỗ này.
Giết vi khuẩn thì quá dễ. Vấn đề là đã sẵn sàng (ăn) hay chưa. Chỉ cần gia nhiệt thực phẩm trên 60 độ C là được. Nhiệt độ đun nấu đi đôi với thời gian. Nhiệt độ cao thì vi khuẩn chết lẹ (thời gian đun ngắn) và ngược lại. Cũng lưu ý, nhiệt độ ở đây là nhiệt độ ở lõi miếng thịt, chứ không phải ở mặt ngoài, và cũng cần lưu ở nhiệt độ đó thêm vài phút để vi khuẩn khỏi ngấp ngoái.
Thức ăn nguội lại, chừng vài ba giờ là vi khuẩn mon men tới. Lại phải ngăn -giết-chặn.
Giữ thực phẩm dưới 5 độ C (từ 1 – 5 độ), tuy không giết được, nhưng làm chậm tốc độ sinh sản của vi khuẩn. Làm chậm không có nghĩa là ngăn chặn (ngăn chặn phải ở nhiệt độ -15 độ C hoặc thấp hơn). Ngăn ngừa nhiễm chéo và trữ lạnh thực phẩm sẽ được đề cập trong số tới.
Một số vi khuẩn chịu lạnh khá tốt, dưới 5 độ C vẫn sinh đẻ ì xèo. Rủi mà may, đa số chúng lại là vi khuẩn gây hư, chẳng hạn loại psychotrophs và psychrophiles. Một số ít vi khuẩn gây bệnh như Listeria monocytogenes cũng tồn tại ở nhiệt độ thấp.
An toàn thực phẩm chỉ nhằm ngăn ngừa tới mức thấp nhất những rủi ro. Thấp tới mức nào là do người tiêu dùng tự bảo vệ. Còn trông chờ vào chính sách vĩ mô hay vi mô gì đó lại là chuyện khác.
Vũ Thế Thành
————–
Vài điểm lưu ý
• Không mua thực phẩm đông lạnh (nấu chín hoặc chưa nấu chín), nếu bao bì bị thủng hay bị rách
• Không mua thực phẩm mà bao bì của chúng bị phồng.
• Không dùng thực phẩm bị mốc, có mùi khó ngửi và màu sắc sậm lại khác thường.
• Không dùng thực phẩm mà khi vừa mở bao bì chất lỏng phụt ra hoặc có bọt
• Không nếm để thử xem thực phẩm có an toàn hay không.
.


Pingback: Hết tuổi thọ nhưng chưa chết | Những thằng già nhớ mẹ
Pingback: Triết lý barbecue | Những thằng già nhớ mẹ
Pingback: Sữa tiệt trùng: bí hiểm công nghệ, sướng cho quảng cáo | Cty Kỹ Thuật Nguyên Thảo